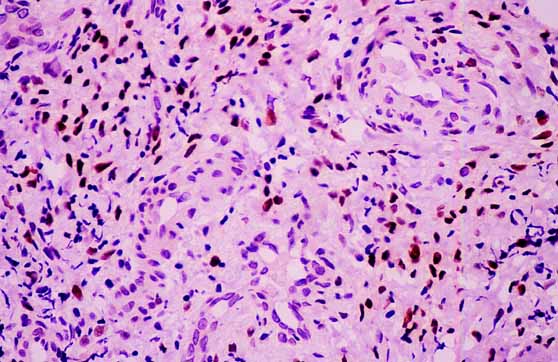
fig. 3

Póster
Nş 086
Póster |
SOGA GARCIA, ELVIRA; REZOLA SOLAUN, RICARDO
 |
| Figura 1.- Grupos celulares con necrosis central, tipo comedo, cubierta en parte por la capa pigmentaria de la retina (HE, 20x) |
 |
| Figura 2.- Filas "indias" de células de carcinoma lobulillar infiltrante (HE, 10x) |
|
| Figura 3.- Receptores de estrógenos positivos (diaminobencidina, 20x) |
 |
| Figura 4.- Acúmulos de células tumorales con patrón cribiforme entre folículos tiroideos (HE, 10x) |
 |
| Figura 5.- Receptores de estrógenos positivos (diaminobencidina, 20x) |